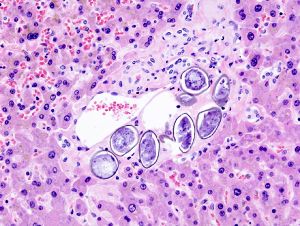
Schistosoma japonicum (3) histopathology.JPG

بلهارسيا (مرض)
| بلهارسيا (مرض) | |
|---|---|
 | |
| حويصلات جلدية على قدم نتيجة إختراق ديدان البلهارسيا. المصدر: CDC | |
| التبويب والمصادر الخارجية | |
| التخصص | الأمراض المعدية (تخصص طبي) |
| ICD-10 | B65. |
| ICD-9-CM | 120 |
| Patient UK | فشل عرض الخاصية P1461: لم يتم العثور على الخاصية P1461. بلهارسيا (مرض) |
| MeSH | D012552 |
البلهارسيا Schistosomiasis أو bilharzia مرض يصيب العديد من الناس في الدول النامية. لا تعد البلهارسا مرضا قاتلا إلا أنها تؤدي الي سرعة استهلاك جسد المصاب. سميت بهذا الإسم نسبة إلى تيودور بلهارس حيث أنه اكتشف سبب الإصابة بالبلهارسيا البولية سنة 1851 م. توجد 5 أنواع مختلفة من الديدان التي تؤدي للإصابة بالمرض.
تعيش ديدان البلهارسيا إذا صادفت عائلاً وسيطاً ألا هو نوع من أنواع قواقع الديدان العذبة وإلا فهي تموت ولا تشكل خطراً.
خصائص المرض
نجم الأشكال الرئيسية لداء البلهارسيات البشري عن خمسة أنواع من الدودات المسطّحة أو الدودات المثقوبة التي تُدعى البلهارسيات، وتلك الأشكال هي:
داءالبلهارسيات المعوي الذي تسبّبه البلهارسية المنسونية والذي ينتشر في إقليمي أفريقيا وشرق المتوسط ومنطقة البحر الكاريبي وأمريكا الجنوبية. داءالبلهارسيات المعوي الشرقي أو الآسيوي الذي تسبّبه الطفيليات من فئة البلهارسية اليابانية (التي تضمّ البلهارسية الميكونغية المنتشرة في حوض نهر الميكونغ)، والذي يتوطن إقليمي جنوب شرق آسيا وغرب المحيط الهادئ. وتم الإبلاغ أيضاً، في بلدان وسط أفريقيا، عن انتشار شكل آخر من أشكال داء البلهارسيات المعوي تسبّبه البلهارسية المُفحمة. ويتوطن داء البلهارسيات البولي الذي تسبّبه البلهارسية الدموية إقليمي أفريقيا وشرق المتوسط. وتدخل البلهارسيات جسم الإنسان من خلال التعامل مع مسطحات الماء الملوّثة بها. ويحدث ذلك خصوصاً لدى الأشخاص الذي يعملون في قطاعي الزراعة وصيد الأسماك. غير أنّ نزوح الناس من الأرياف إلى المناطق الحضرية يسهم حالياً في إدخال المرض إلى أرباض المدن في شمال شرق البرازيل وأفريقيا، ويسهم تنقّل اللاجئين في نقله إلى مناطق أخرى. كما يُسجّل تزايد في إصابة السائحين بداء البلهارسيات، وذلك مع زيادة السياحة الإيكولوجية والرحلات البعيدة عن المسالك السياحية المألوفة، علماً بأنّ تلك الإصابات قد تكون وخيمة وحادة في بعض الأحيان وتتسبّب في حدوث مشاكل غير معهودة، مثل شلل الساقين.
والجدير بالذكر أنّ داء البلهارسيات يخلّف آثاراً اقتصادية وصحية كبيرة. فهذا المرض يعرقل الأداء المدرسي وأنماط النمو لدى الأطفال المصابين به، على الرغم من إمكانية تدارك الوضع بالعلاج. كما يمكنه التأثير، في بعض الحالات، في قدرة الشخص على العمل.
التشخيص
لتشخيص داء البلهارسيات البولي تُستخدم إحدى تقنيات الترشيح القائمة على استعمال ورق الترشيح أو البوليكاربونات أو المرشحات المصنوعة من النيلون. ويمكن العثور لدى الأطفال المصابين بالبلهارسية الدموية، في معظم الحالات تقريباً، على كمية مجهرية أو مرئية من الدم في عيّنات البول (البيلة الدموية). ويمكن أيضاً تحديد الأطفال الذين ينبغي علاجهم عن طريق فحص عيّنات البول أو تحرّي كميات الدم المجهرية في البول باستخدام أشرطة الكواشف الكيميائية. كما يمكن استفسار الأطفال عمّا إذا سبق لهم ملاحظة دم في بولهم وذلك من أجل تحديد المجتمعات المحلية المعرّضة لأكبر مخاطر الإصابة بالعدوى. ويمكن الكشف عن بيض البلهارسية المعوية في عيّنات البراز وذلك عن طريق تقنية تقوم على استعمال مادة السيلوفان المنقوعة في الغليسيرين، أو بين شريحتين زجاجيتين.
أعراض البلهارسيا
أعراض المرض هى:
أعراض المرض تختلف حسب مراحل حياة البلهارسيا بالجسم:
عند اختراق الجلد
فى الغالب يكون ذلك غير محسوس ولكن بعض الاشخاص قد يعانون من حكه في الجلد.
عند افراز البيض
فى الغالب يكون ذلك غير محسوس. ولكن بعض الأشخاص يعانون من حرارة حكة بالجلد قد يصحبه ارتفاع بكريا الدم البيضاء (Eeaosinophilia)
عند ترسيب البيض
عند ترسيب البيض يحدث تليف في أنسجة الكبد يتم ذلك بدون احساس المريض بأية أعراض حتىتبدأ مرحلة متقدمة بأعراض ارتفاع ضغط الدم البابى 'وتبدأ وظائف الكبد بالتدهور. ويحدث نزيف معوى وتضخم بالبطن بسبب السوائل. ويسبب أيضا تليف في جدار المثانة. وترسب الكالسيوم خلال هذه الفترة ينتج عنه حدوث نزيف مع البول حيث يتلون باللون الأحمر. قد يحدث انسداد في الحالب من احدى الكلى أو كليهما مما يؤدى إلى فشل كلوى في بعض الحالات يتطور الأمر الى الإصابة بسرطان المثانة.
العلاج
البرازيكوانتيل (Praziquantel) هو العلاج المتاح والناجع الوحيد ضد جميع أشكال داء البلهارسيات، والجدير بالذكر أنّ هذا الدواء لا يتسبّب إلاّ في حدوث بعض الآثار الجانبية العابرة. ويبلغ سعر القرص الواحد (600 ملغ) نحو 08ر0 دولارات أمريكية، كما يتراوح سعر العلاج المتوسط بين 20ر0 و30ر0 دولاراً أمريكياً. وعلى الرغم من احتمال الإصابة بالعدوى مجدّداً بعد العلاج، فإنّ مخاطر إصابة أعضاء الجسم بحالات مرضية وخيمة تتقلّص بتعاطي الأدوية، بل إنّها تنحسر لدى صغار الأطفال. وبات من الممكن، في معظم المناطق، خفض العدد الإجمالي للحالات وإبقائه منخفضاً طيلة 18 إلى 24 شهراً، وقد تمتد تلك الفترة إلى خمسة أعوام تقريباً في مناطق أخرى دون الاضطلاع بتدخلات إضافية. [1]
القضاء على قواقع البلهارسيا
يجب القضاء على قوقع البلهارسيا وبذلك يتم التحكم في المرض. يتم القضاء على القوقع بطريقتين:
التحكم العضوي الطبيعي
يتم ذلك النوع بتربية البط وأنواع أخرى من الطيور المائية التي تتغذى على القواقع ، ويتميز هذا النوع من التحكم البيولوجي بأنها لا تضر البيئة بل تخدمها بتحقيق نوع من التوازن الطبيعي.
التحكم الكيميائي
يتم ذلك برش مبيدات حشرية خاصة في المجاري المائية للقضاء على القوقع ، إلا أن ذلك يلوث البيئة.
انظر أيضاً
المصادر
قراءات إضافية
- Brasil. Ministério da Saúde. Secretaria de Vigilância em Saúde. Departamento de Vigilância Epidemiológica. 2007. Vigilância e controle de moluscos de importância epidemiológica : diretrizes técnicas : Programa de Vigilância e Controle da Esquistossomose (PCE). Ministério da Saúde, Secretaria de Vigilância em Saúde, Departamento de Vigilância Epidemiológica. 2. ed. Brasília : Editora do Ministério da Saúde. 178 pp. ISBN 978-85-334-1438-9. (in Portuguese) (Surveillance and Control of Mollusks with Epidemiological Importance: technical directives: Schistosomiasis Control and Surveillance Program)
وصلات خارجية
- CDC Yellow Book Entry
- World Health Organization Partners for Parasite Control website
- World Health Organization fact sheet on the disease
- Wellcome animation of the life cycle of the parasite
- Schistosomiasis Control Initiative
- CONTRAST, a research project on optimized schistosomiasis control in Sub-saharan Africa
- World Health Organization Tropical Disease Research programme
- Cambridge University Schistosomiasis Research Group
- York University Schistosomiasis Research Group
- The Carter Center Schistosomiasis (Bilharzia) Control Program
- Links to Schistosomiasis pictures (Hardin MD/Univ of Iowa)
- FIOCRUZ — Schistomiasis Research Group
- Sandler Center for Basic Research in Parasitic Diseases, University of California San Francisco
- Vacine developed in Queensland, Australia
ْْ